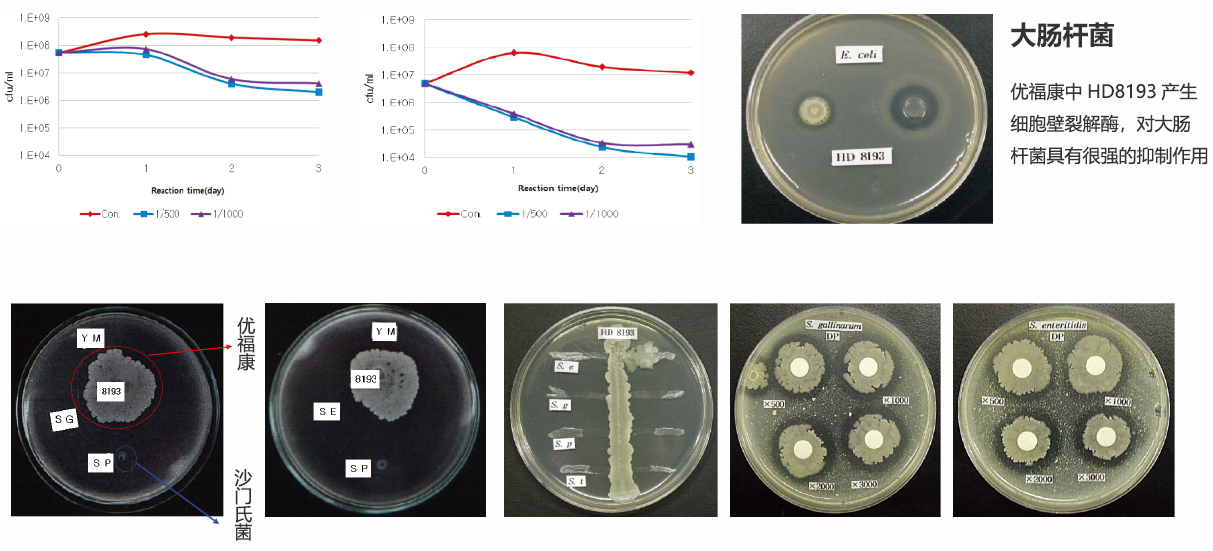

产品简介:
优福康是采用特殊工艺筛选出的韩国基源的强抗菌活性系统微生物与酶的复合制剂,含有≥1.0×109cfu/g益生菌(枯草芽孢杆菌HD8193、5833、8015、3168和5442),及乳酸菌、酵母菌等天然微生物,蛋白酶、淀粉酶、脂肪酶、半纤维素酶和β-半乳糖苷酶等。
产品特性:
韩国专利菌种:含有数十亿高纯度枯草芽孢杆菌,具有超高复活率,在体内能保存8~24小时高繁殖率;
抗微生物活性:分泌细胞壁裂解酶分解细菌细胞壁,调节肠道菌群平衡
环保:显著降低氨气,净化禽舍环境
分泌消化酶:酶:蛋白酶、淀粉酶、半纤维素酶、壳多糖酶等
维生素、抗菌素:维生素类:维生素B、K、生物素、烟酰胺;抗菌剂:杆菌肽、粘菌素、枯草菌素
抗逆性强的芽孢:高热稳定性,高存活率,酸碱稳定性:在pH值从1~12变化,较高的存活率
全面环境改良:增强肠胃功能、减少肠道疾病、提高饲料转化率。净化体内外环境,建立良好微生态系统,提高免疫力,减少粪便排出量,溶解蝇蛆虫卵,从源头解决圈舍空气质量,建立养殖友好环境

优福康生物菌能降低肠氨浓度,改善肠道内环境,减少毒素产生;能调节动物胃肠道微生态环境,调整菌群平衡,形成生物屏障抑制有害菌的生长繁殖,促进动物生长,达到提高动物免疫力和降低死亡率的功效

优福康的热稳定性:

优福康酶的活性:
优福康具有很强的产酶能力:蛋白酶、淀粉酶、纤维素酶和植酸酶等。

优福康的体外作用:
优福康对沙门氏菌有很强的抑制作用
优福康和抗菌剂兼容性的体外测试:

优福康在胃肠道的稳定性试验:

用法与用量:
饲添:每吨饲料添加优福康200~300克。
包装规格:1kg*20包/箱、20kg/袋
有效期:2年
一、广东6000头保育猪2011年10月 优福康对比试验结果




二、优福康在母猪上的应用试验
1.试验
1.1 试验材料
选取配种时间接近、胎次大致相同、健康状况良好的产前5d的二元杂(长白x杜洛克)经产母猪26头。
优福康由优默生物提供,添加剂量根据生产厂家建议确定。

1.2 试验设计
试验随机分为2个处理组,每个处理组13个重复,每个重复1头母猪。
对照组饲喂哺乳期基础日粮,试验组饲喂哺乳期基础日粮+优福康200g/t,产仔25d后试验结束。
1.3 饲养管理
试验于2018年7.5-8.7(产前5d-25d日断奶)在广东某生猪养殖基地开展。
进行母猪繁殖性能及仔猪生长性能、采食量、粪便情况等相关指标的测定。
2.结果与结论
2.1 优福康对母猪繁殖性能及仔猪生长性能的影响

2.2 优福康对母猪平均日采食量的影响

2.3 优福康对母猪粪便形态及评分的影响

2.4 结论
在繁殖母猪中使用优福康对母猪繁殖性能无显著影响;
极显著提高产前5d到产仔后25d母猪的采食量;
明显改善母猪的粪便形态,极显著提高哺乳母猪粪便评分,降低便秘发生率。
优福康
—— 益生菌及酶复合制剂
是一种特制的微生态制剂,也是一个针对性的益生素,是维持肠道菌群平衡的有益微生物。

优福素:
韩国泡菜中的乳杆菌、明串球菌、魏斯氏菌发酵代谢产物提取的新型免疫多糖、抗氧化酸性多糖等成份,调节、平衡肠道菌群等多样性有益菌及代谢物协同优福素活性物质快速激活机体自身的免疫识别和监管,同时达到强力抵抗肠道内有害菌、抑制和清除病毒等。
优酸肥
—— 复合有机酸、果寡糖、植物精油、霉菌毒素中毒解毒剂等

当前母猪养殖上面临的常见问题
一、问题及其危害
韩国泡菜中的乳杆菌、明串球菌、魏斯氏菌发酵代谢产物提取的新型免疫多糖、抗氧化酸性多糖等成份,调节、平衡肠道菌群等多样性有益菌及代谢物协同优福素活性物质快速激活机体自身的免疫识别和监管,同时达到强力抵抗肠道内有害菌、抑制和清除病毒等。
1、便秘
①采食下降、影响胎儿发育;
②泌乳不足,影响仔猪生长、拉稀、增加死亡率;
③直肠过多吸收粪便毒素,引起免疫下降、增加疾病感染率
2、母猪奶水不足危害
①仔猪腹泻增加;
②奶水中母原抗体不足;
③仔猪吃不到初乳导致饿死,死亡率提高;
④仔猪生长性能下降
3、产程过长危害
①产死胎(白死胎)显著增多,弱仔增多,仔猪成活率下降,发病率高,断奶窝重下降;
②导致母猪体能消耗过大,过度疲劳,出现产后厌食、不吃、母猪产后少乳、无乳,母猪奶水质量差,仔猪腹泻,大小不均匀;
③导致恶露不尽、影响子宫壁的恢复,最终形成子宫炎症,缩短母猪生产年限;
④导致断奶后母猪配种率低、返情增多。
二、问题解决途径——“三优方案”
优福素1kg/t +优福康200g/t(怀孕90天用至断奶)
优酸肥1kg/t+优福康300g/t(怀孕90天用至断奶)
“三优方案”母猪保健临床效果:
①减少便秘、促进采食,缩短产程;
②促进泌乳,提高断奶仔猪体重;
③降低返情,提高配种率;
④减少蓝耳、圆环等繁殖障碍疾病的感染压力,提高母猪健康免疫力。

当前仔猪养殖面临的主要问题
一、问题及其危害
1、初生重低:子宫内发育迟缓是由于营养与激素不足引起妊娠期胚胎和胎儿器官发育迟缓,从母体向胎儿转运的养分和氧气不足会降低胎儿的生长速度,从而引起仔猪初生重低及补偿生长潜力低;
2、抗病力弱:新生仔猪消化器官不发达,免疫功能不完善,缺乏先天性免疫力,抗病力弱;
3、腹泻率高:猪场病毒、细菌感染压力大,仔猪免疫力低,亚健康比例高,仔猪腹泻率高发,死淘率居高不下。
二、问题解决
保育前期(2-3周):优福素2kg/T+优福康300g/T, 利多安保育前期1-2ml/天/头用10天;
保育期:优福素2kg/t+优福康300g/t+优酸肥1kg/t
三、“三优方案”仔猪保健临床效果
①建立肠道优势菌群,促进肠道健康,降低腹泻率;
②强效抗病毒,提升机体免疫力,降低死淘率;
③减少弱仔,提高生长速度 ;
④提升机体免疫力。
